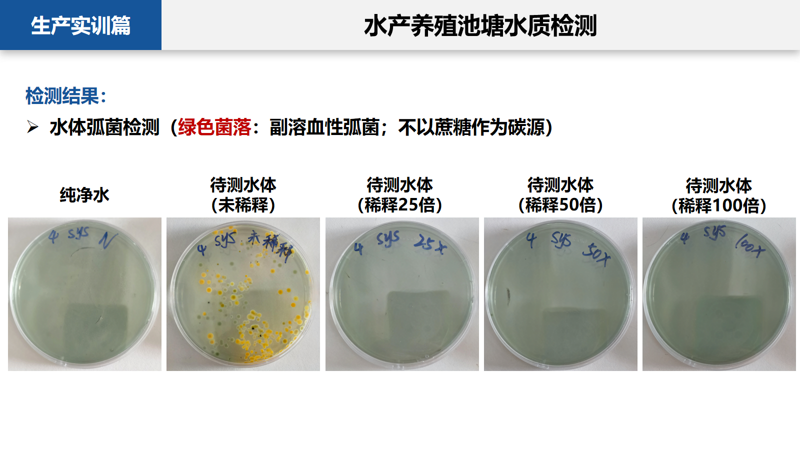

2024年度水生生物学生产实习丨深蓝之旅:探秘水产行业的未来与创新
前言
习近平总书记多次强调“海洋是高质量发展战略要地”,指出“要加快海洋科技创新步伐,提高海洋资源开发能力,培育壮大海洋战略性新兴产业”。
身为生命科学领域的学习者,自然需要积极响应总书记的号召。2024年7月9日至24日,中山大学生命科学学院水生生物学生产实习如期开课。在何建国教授教学团队的带领下,2021级生物技术专业本科生走出“舒适区”,走进生产第一线。辗转广州、珠海、吴川、湛江等地,感激有各地专家领导的分享与实操,同学们深刻体悟到肩上的重任,立志投身于国家重大战略方向,为我国科技自主创新贡献“生科力量”。
01
生产实践篇
种业资源的保护
海洋资源并非予取予求。广州市水生野生动物保护基地提供了讲座与实地考察讲解。通过专家全面的介绍,我们了解如何通过资源调查、栖息地管理生境调查、圈养个体人工养殖、遗传学研究、归野等手段保护珍稀濒危动物。我们也参观了基地救护工作的开展情况,乐见中华鲟、花鳗鲡、胭脂鱼、黄喉拟水龟等重获新生。





广州市水生野生动物保护基地所救护的水生野生生物
水产养殖行业
苗种选育与饲料生产是水产养殖的重要环节,其产业链的高自主性与高韧性,对于“端好中国饭碗”不可或缺。
广东恒兴饲料实业股份有限公司走过三十年发展征程,下设多个饲料厂。我们在饲料厂不仅近距离接触“巨无霸”的机器,更在预混料厂跟随讲解员,了解高度智能化、自动化的物流仓储管理体系,切身感受信息科技为饲料生产带来的效率与便利。


广东恒兴饲料实业股份有限公司的饲料工厂
同时,饲料监测是供给端食品安全的保证。在恒兴检测中心,我们见到了大量先进灵敏的检测仪器,更深入学习相关团队如何利用人工智能技术加快检测效率,对水产养殖安全更有信心。

恒兴检测中心
种源安全关系到国家安全。习近平总书记多次指示,必须下决心把我国种业搞上去,实现种业科技自立自强、种源自主可控。广东恒兴集团有限公司胡一丞等前辈,针对对虾育种进行了精彩讲解。我们回顾了南美白对虾知识产权自主化的历程,领悟老一辈科学家的专注与创新精神;同时也更熟悉当前利用分子生物学技术,结合免疫通路改良品种的新手段。

广东恒兴育种成果
海鲈与罗氏虾是当前热门水产品。珠海粤顺水产养殖有限公司瞄准海鲈养殖,珠海斗门区乾务镇庆隆养殖场聚焦于罗氏虾养殖,不断改进养殖工艺,同时与有关科研机构保持合作,借助科技力量提质增产。

海鲈养殖场

罗氏虾养殖场

从水塘中捞出的罗氏虾
水产养殖行业的数字化智能化趋势正在加快。广州市诚一水产养殖有限公司借助物联网等高新科技,搭建了智能化渔业装备与管理互联系统,帮助其他企业进行数字化转型,推动我国“汗水渔业”到“智慧渔业”的产业升级。

广州市诚一水产养殖有限公司参观
水产品加工行业
加工链的完善整合,是水产品惠及千家万户的关键原因。国联水产集团是其中的佼佼者。我们亲身参观其现代水产品生产线,不仅惊叹自动化程度之高,更在层层质控分拣中感受高标准。

水产品加工行业
预制菜与当前餐饮业需求契合,市场蓬勃发展。国联水产集团的谢燕老师倾囊相授,从自身招牌产品出发,深度解析业内发展现状。当今全球经济增长放缓,国内外市场竞争烈化,消费市场嬗变。国联与众多水产企业一道,不仅需在传统赛道持续发力,更需及时接受下游市场需求的传导,高效实现创新,寻找新的破局点。

谢燕老师正在讲解国联水产集团产品的生产及销售过程

国联水产集团的招牌产品
海洋探索
海洋探索是人类永恒的主题。我们有幸登上了“珠海云”号无人科考船。“珠海云”号是全球首艘具有远程遥控、开阔水域自主航行功能的科考船。科考船配备大量尖端设备,能够进行深海探测、海洋生物采样和海洋环境监测等多项任务。它不仅是我国海洋探索科技自主化的典例,更是解决当前难题的利器。

“珠海云”号现代化、智能化无人科考船
此外,位于珠海校区的南方海洋科学与工程广东省实验室,令我们大开眼界。南方海洋实验室通过“1+N”协同建设,有效整合了大量社会资源,体现了我国向海洋进发的宏图伟略。

南方海洋科学与工程广东省实验室投影展览
“珠海云”号无人科考船模拟舱

南方海洋实验室海洋生物资源库模型
02
生产实训篇
纸上得来终觉浅,绝知此事要躬行。感谢国家863计划项目海水养殖种子工程南方基地,为我们提供了丰富的实践机会。我们顺利开展了硬骨鱼类和虾类的形态观测与解剖、南美白对虾重要病原检测、鱼类电子芯片标记、水产养殖池塘的藻类观察、水产养殖池塘水质检测等多种实验。我们不仅了解真实养殖场景下的操作,更提升了对于生命科学的自豪感。

生产实训的实验结果展示
03
课堂育人篇
党政教育
广东是中国民主革命的重要阵地。湛江寸金桥公园是湛江爱国主义教育基地。园内矗立的抗法英雄纪念像与革命烈士纪念碑,记载了清朝末期湛江人民抗法斗争的光辉历史,承载了湛江人民爱国爱乡的记忆。正如郭沫若先生为寸金桥的题词“一寸河山一寸金”,我们需铭记历史,不忘初心,学习与传承革命精神。

湛江市赤坎区寸金桥公园
东海岛园区党群服务中心秉承“以人民为中心”和“党建引领高质量发展” 的核心理念,融合了海岛文化、地域特色、红色基因以及党建元素。其中不乏全息影像等科技手段,还原历史细节。我们也潜移默化地接受了红色洗礼。

湛江市东海岛园区党群服务中心
企业精神
习近平总书记强调,“市场活力来自于人,特别是来自于企业家,来自于企业家精神。”广东恒兴集团有限公司便是其中的典例。陈丹董事长始终坚守初心,“一辈子做好一件事就行,就是把农业做好,把这条产业链做好”。
恒兴紧跟国家发展战略,用科技引领创新,与中山大学、中国科学院南海海洋研究所等科研机构保持长期合作,在南美白对虾、石斑鱼等育种方面率先取得突破。一方水土养一方人。恒兴富有社会责任感,目前慈善公益活动的累计捐款超3亿元,以实际行动回馈社会。

恒兴集团总部企业文化展厅
美学培育
我们也前往东海岛龙海天沙滩寻找美丽的贝壳,并制作了水晶滴胶工艺品,记录生活中的美好。

在龙海天沙滩寻找贝壳

水晶滴胶工艺品展示
总结与感悟
2024年度水生生物学生产实习让我们收获颇丰。我们不仅深入自然环境,亲身体会自然资源和自然保护的重要性,而且在水产养殖和水产品加工一线中参观学习,全面体悟我国在海洋科研探索领域的战略与成果。
对于水产养殖和水产品加工行业,我们看到:水产动物养殖的自动化趋势正不断加速;为了实现病毒防控、提升产品质量,企业会不断进行设备升级;预制菜的生产正逐步规范化,争取摆脱“不安全”的标签;企业也不断创新,在保证饮食安全的前提下,尝试提升产品的鲜味和口感。
对于海洋科研探索,我们看到:“珠海云”号无人科考船的诞生,为传统海洋观测模式带来了革命性改变,能够自主承担多项科考任务;南方海洋科学与工程广东省实验室作为创新前哨,肩负着海洋牧场与健康养殖、海洋工程与智能装备、海洋安全与防灾减灾、海洋生态环境与碳汇主题相关的重要任务。
通过本次实习,我们明白,自己在学校所学习的生命科学知识和技术,并不是脱离实际的空谈或技艺,而是真真切切能够指导生产、服务生产的工具。
当然,这一切都离不开教学团队中的各位老师与助教师兄师姐的不懈努力,是他们的辛勤付出,换来了我们周全的教学计划,也换来了我们在外的安全。此外,实习的顺利进行也离不开相关企业的支持,他们为我们提供了良好的食宿条件、实验设备与场地、以及参观过程中的讲解。在这里,我们向为水生生产实习付出的每一个人致以最诚挚的谢意。
我们相信在学院、教学团队以及相关企业齐心协力的努力下,这门课程仍将继续进步,越办越好!


